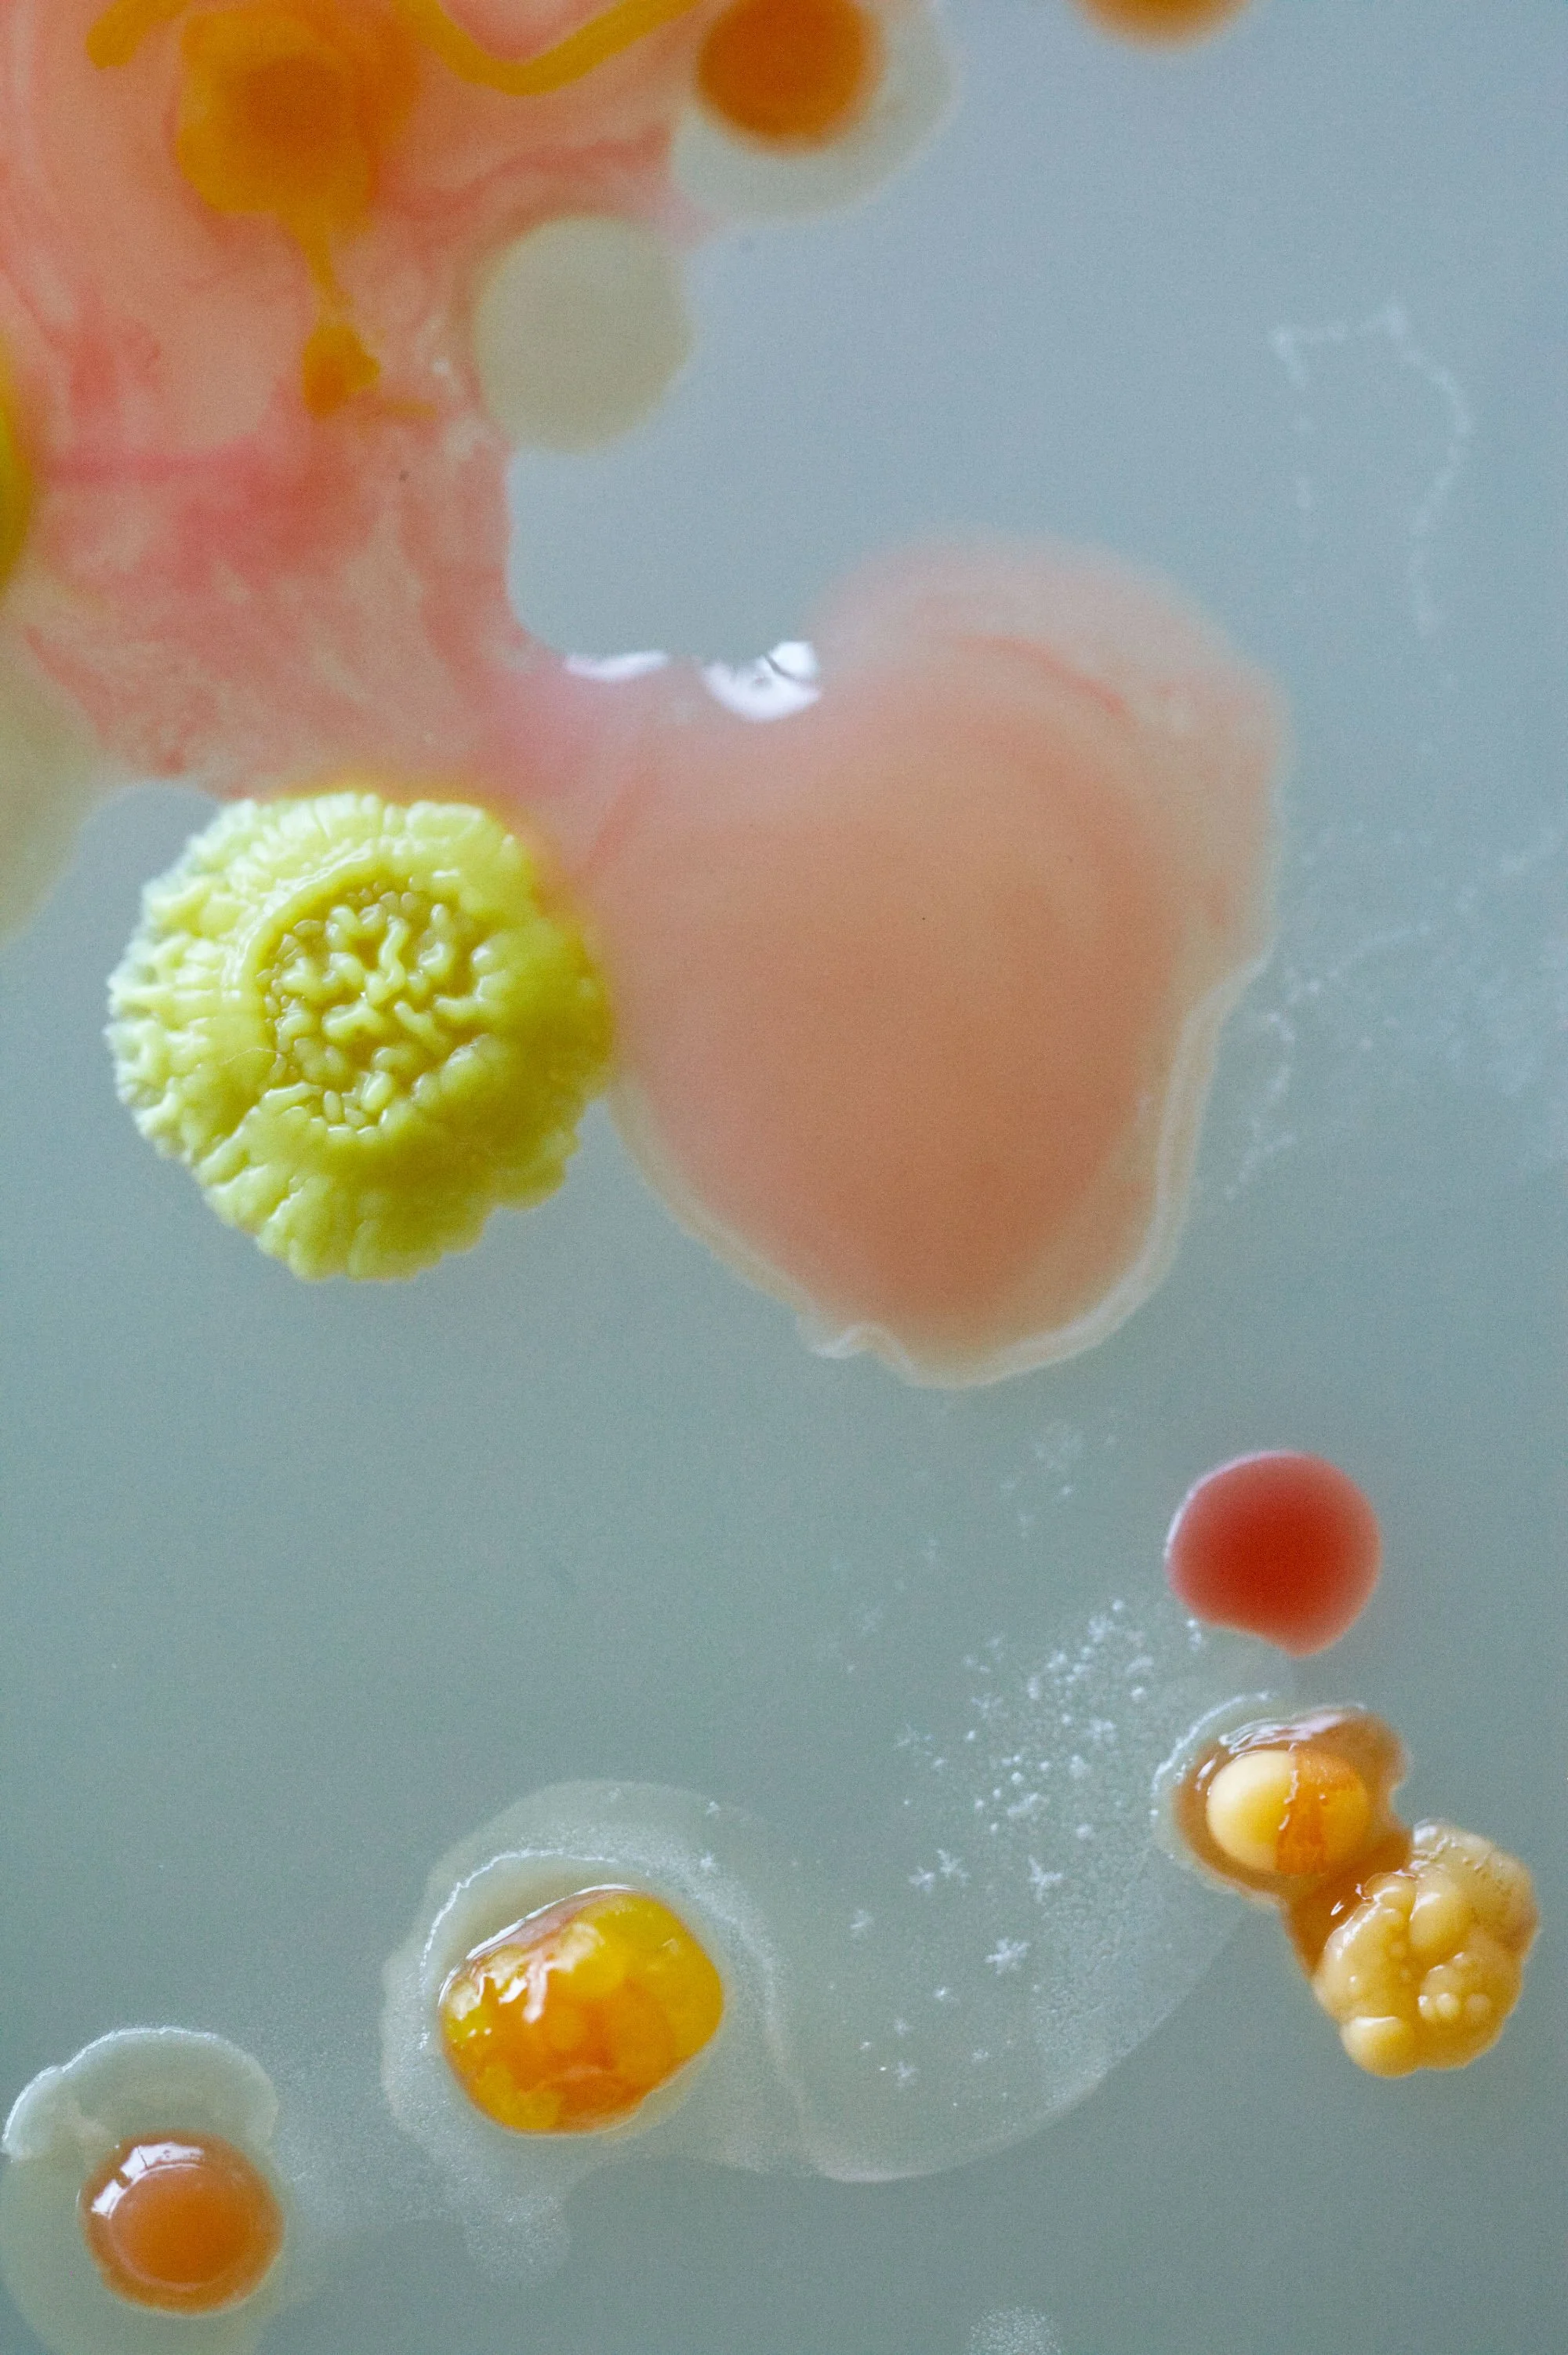
25-02-26 PRINTBESTAND 01.jpg
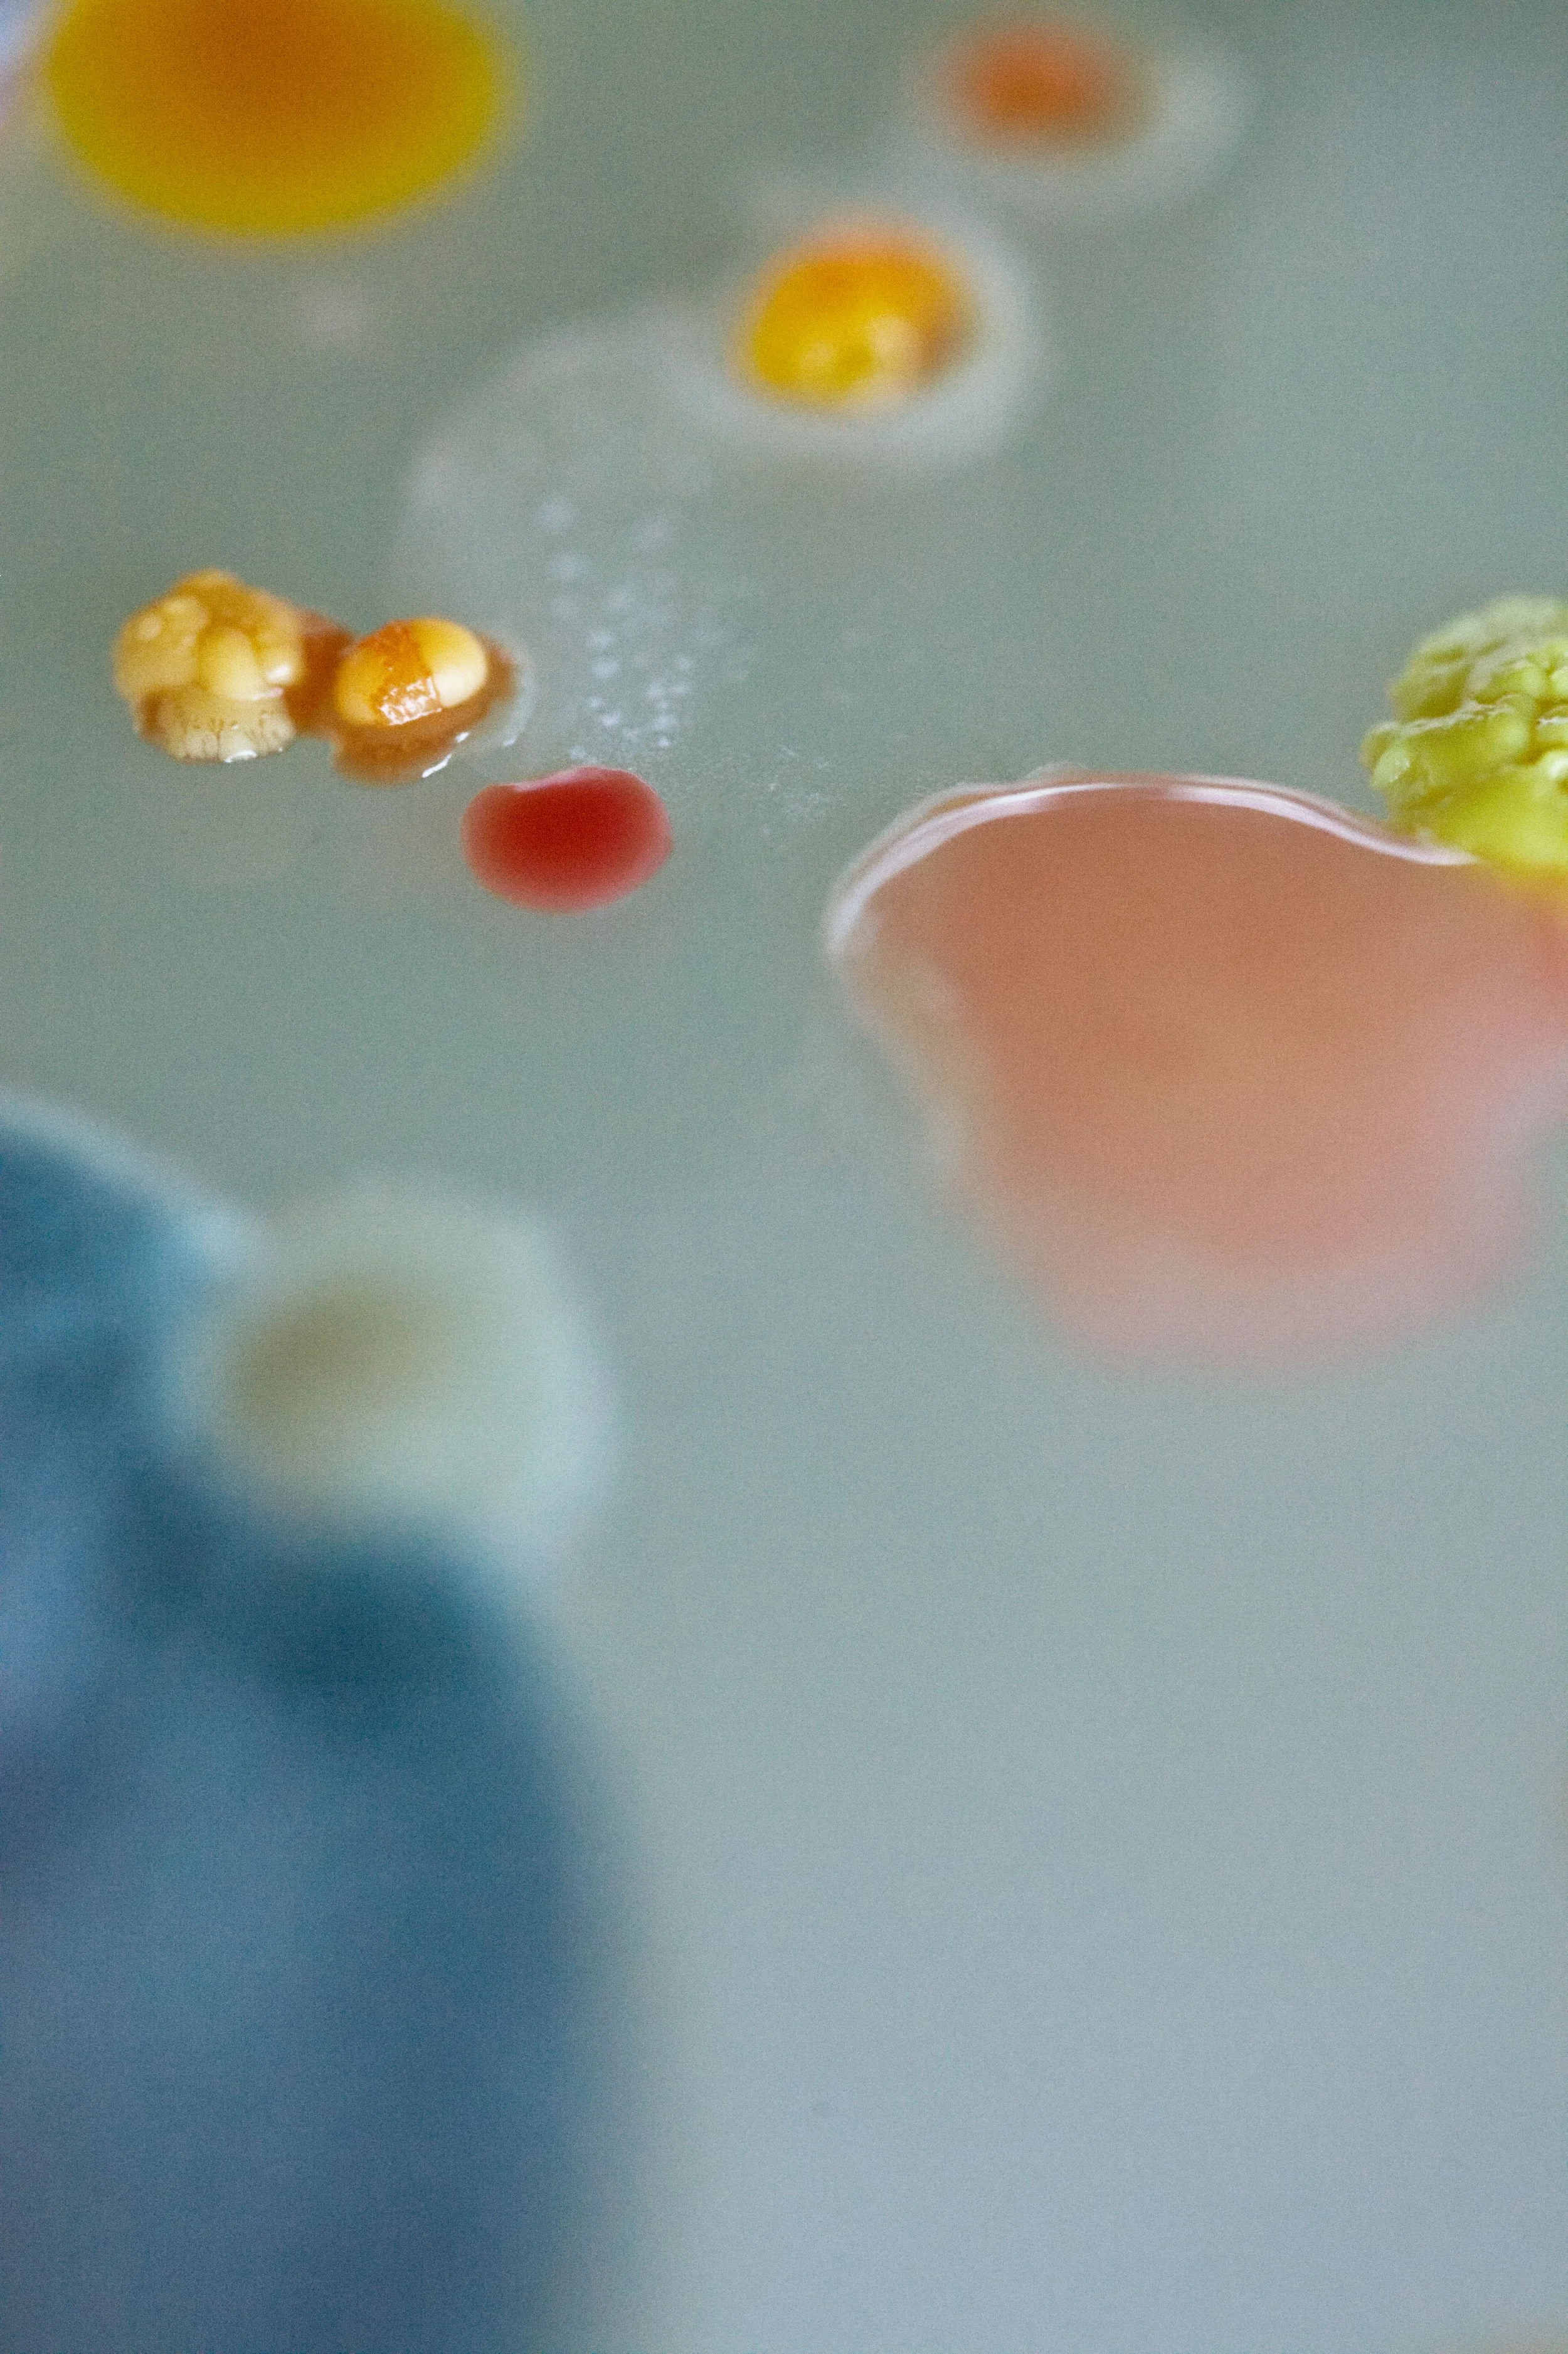
25-02-26 PRINTBESTAND 03.jpg
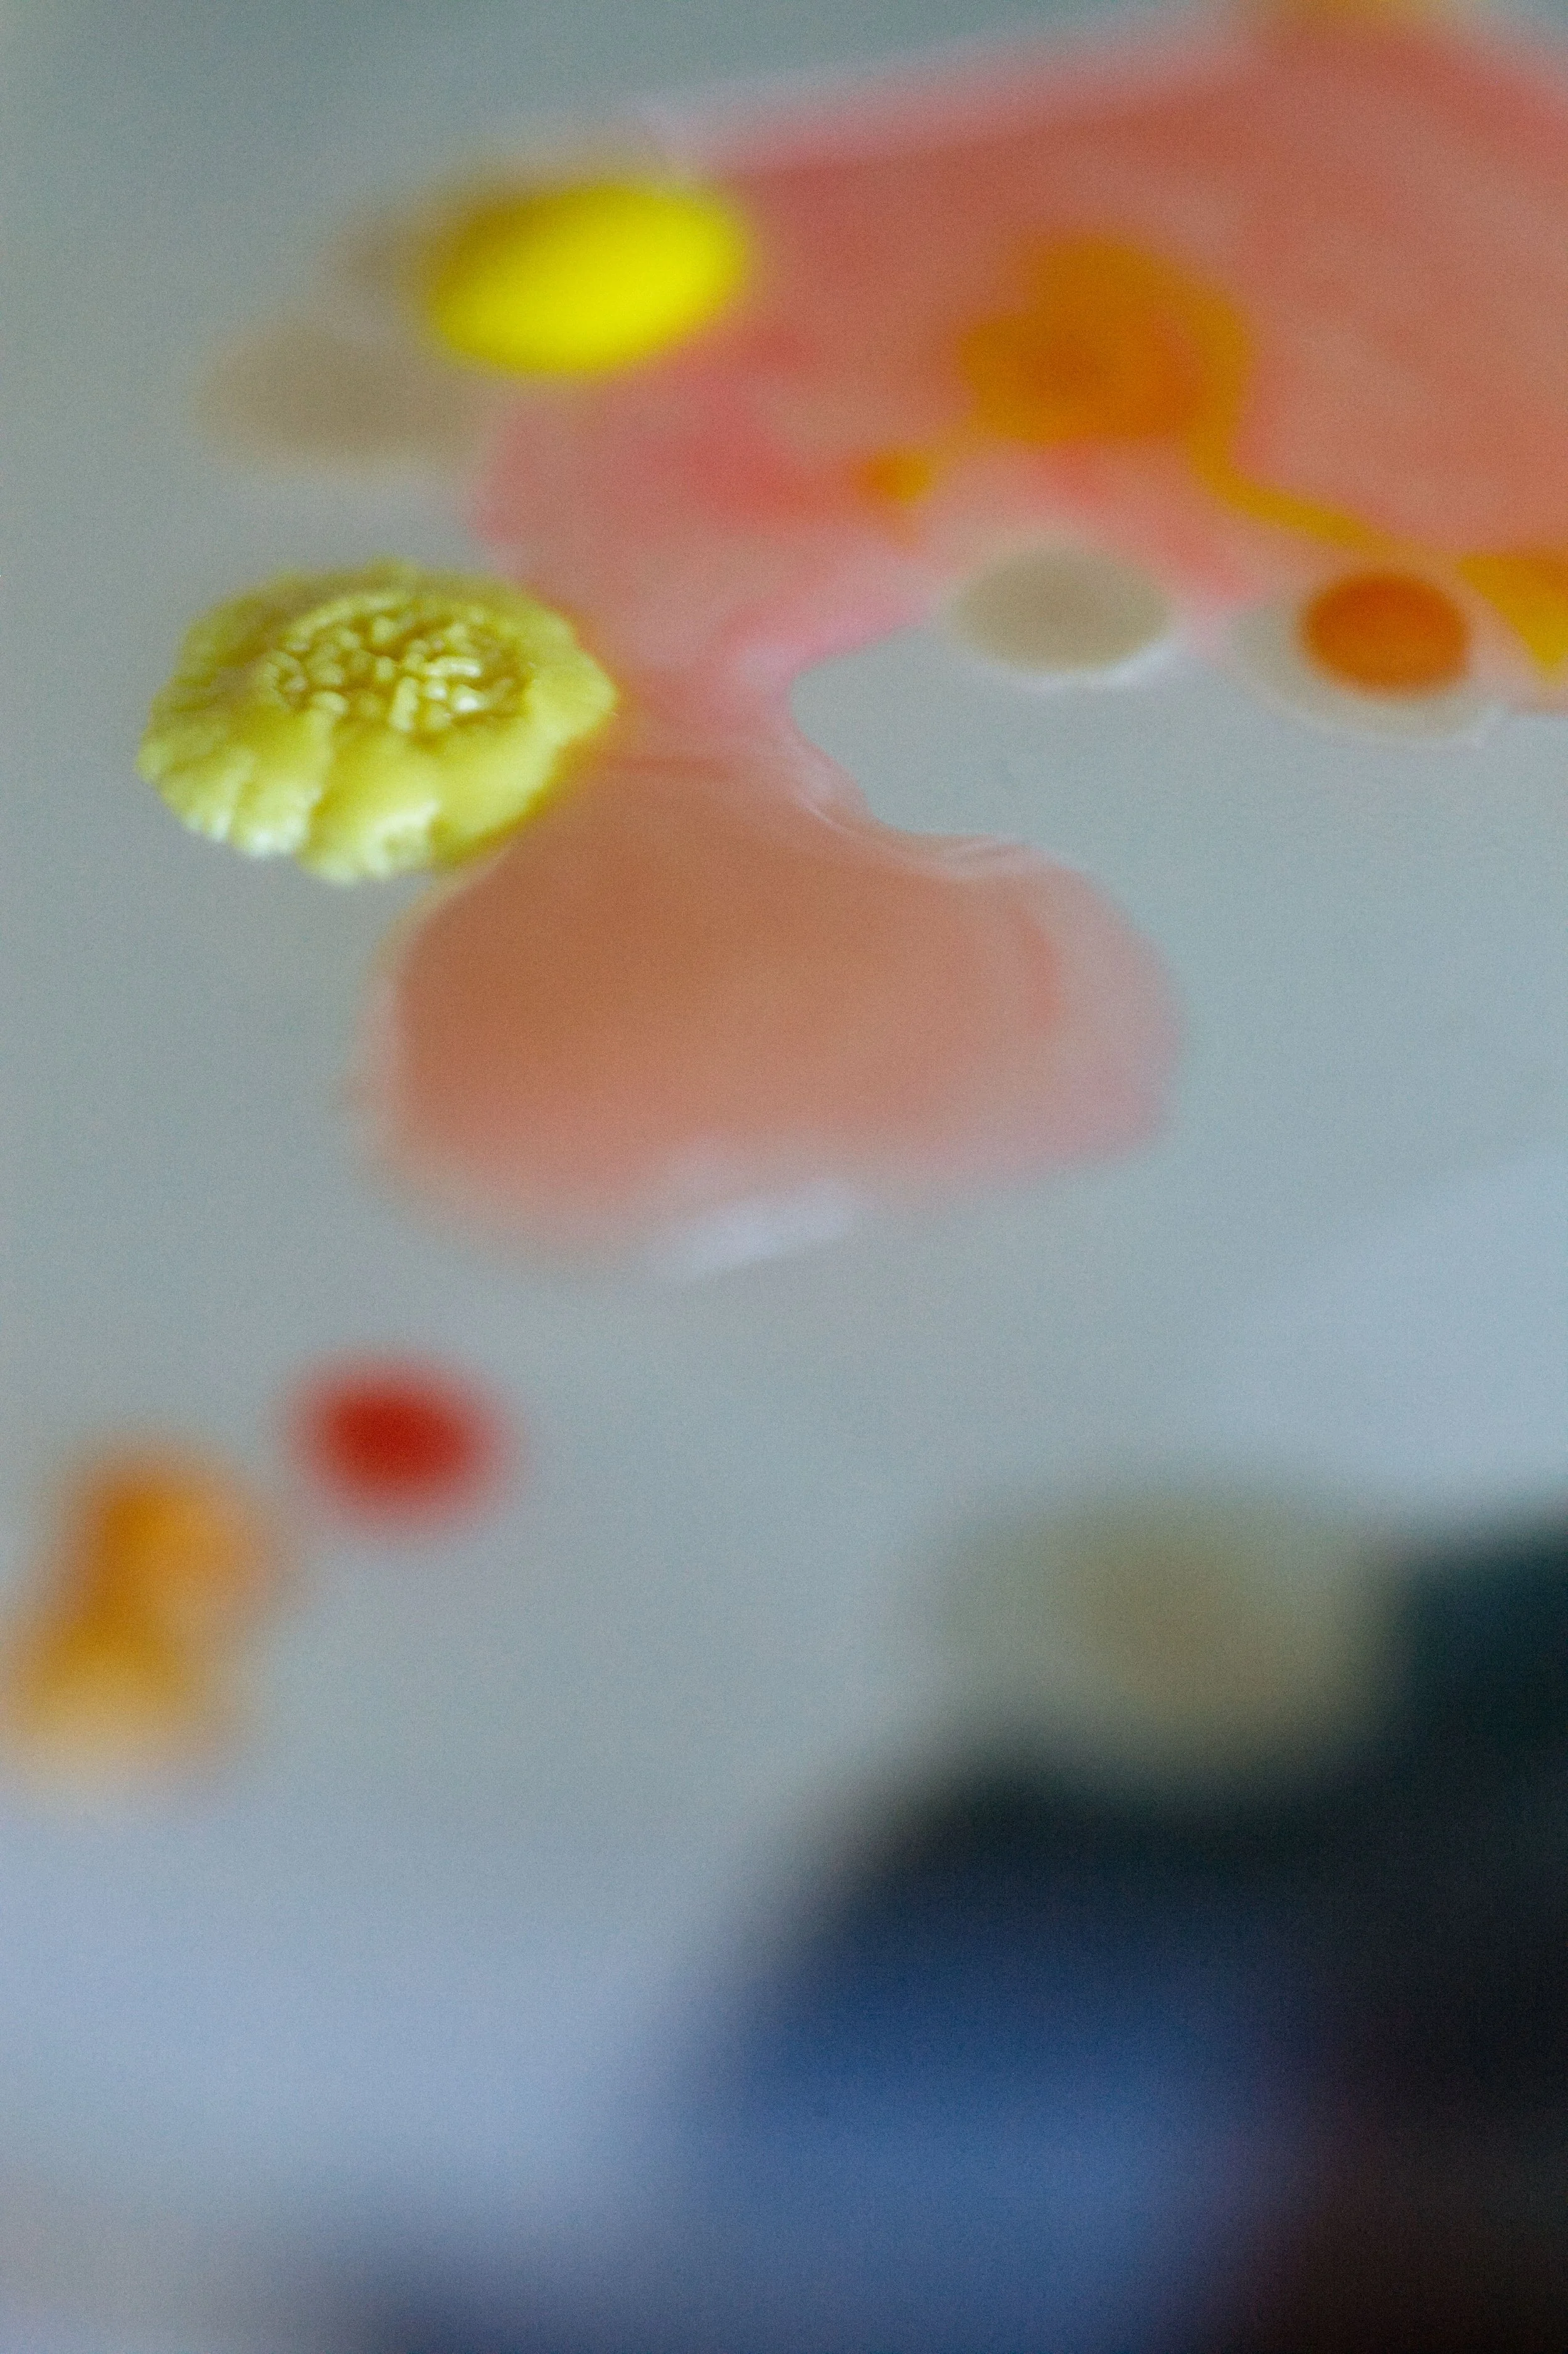
25-02-26 PRINTBESTAND 02.jpg
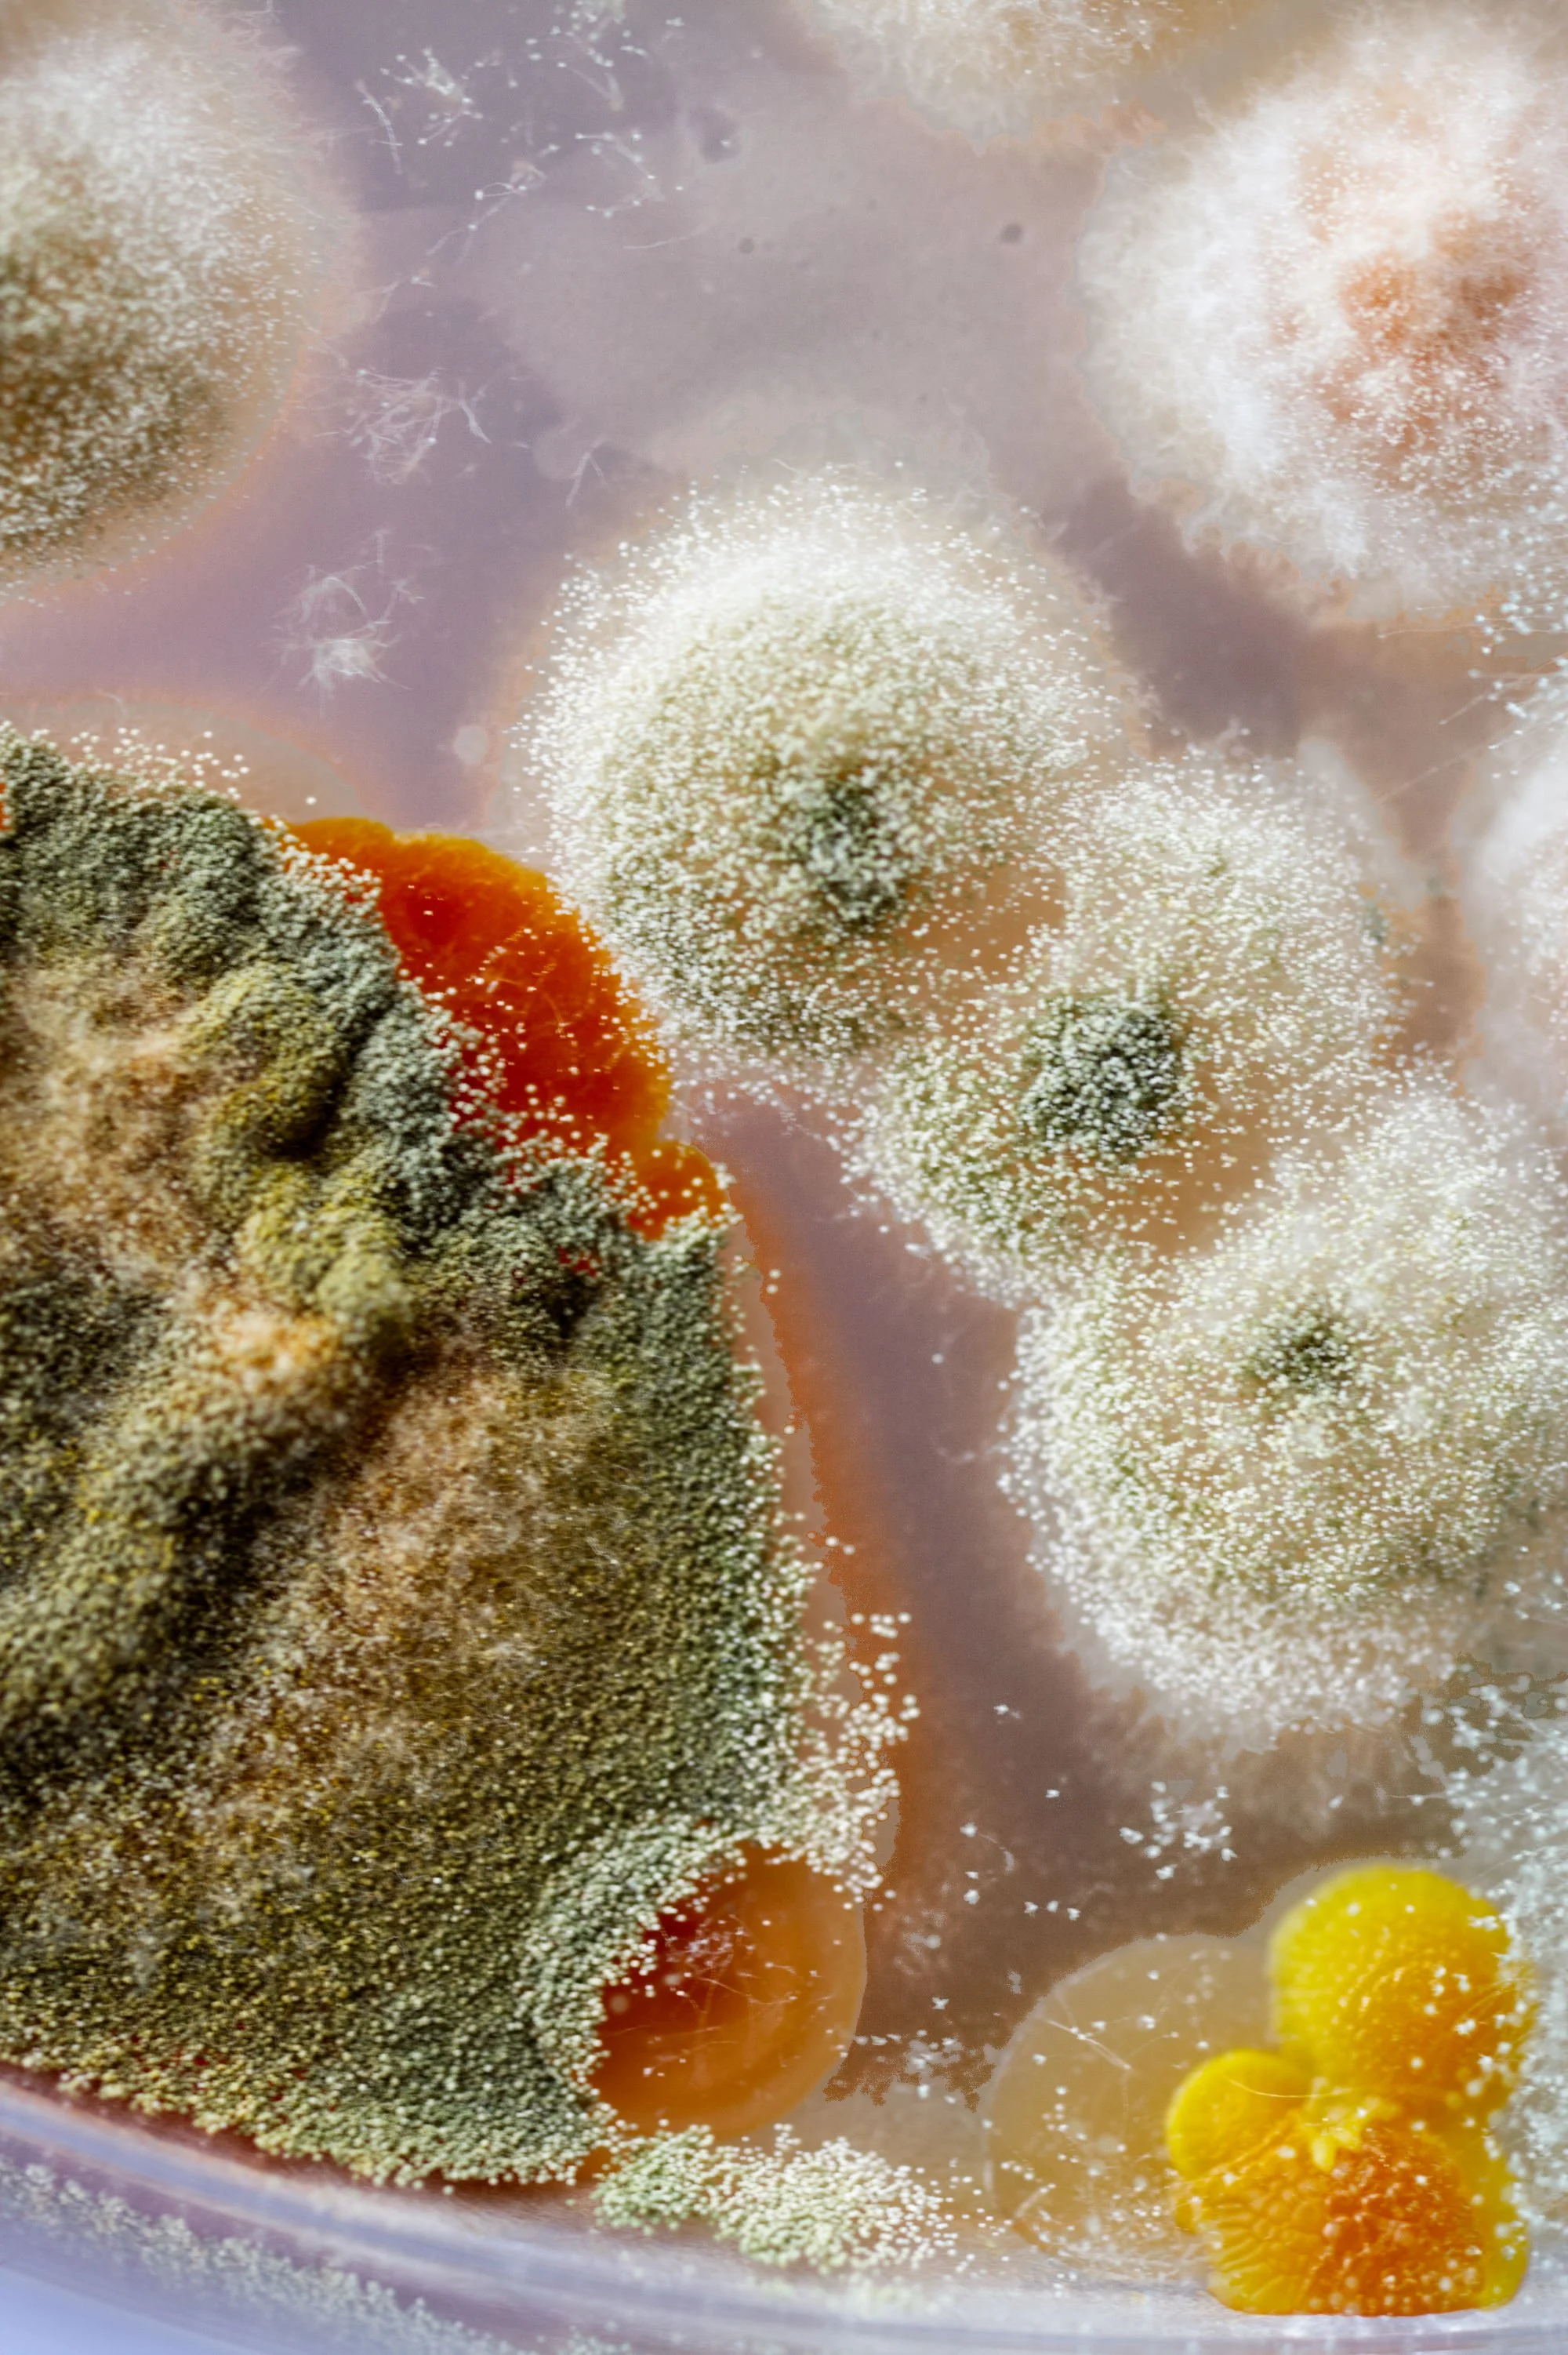
IMG_0029 0026.jpg
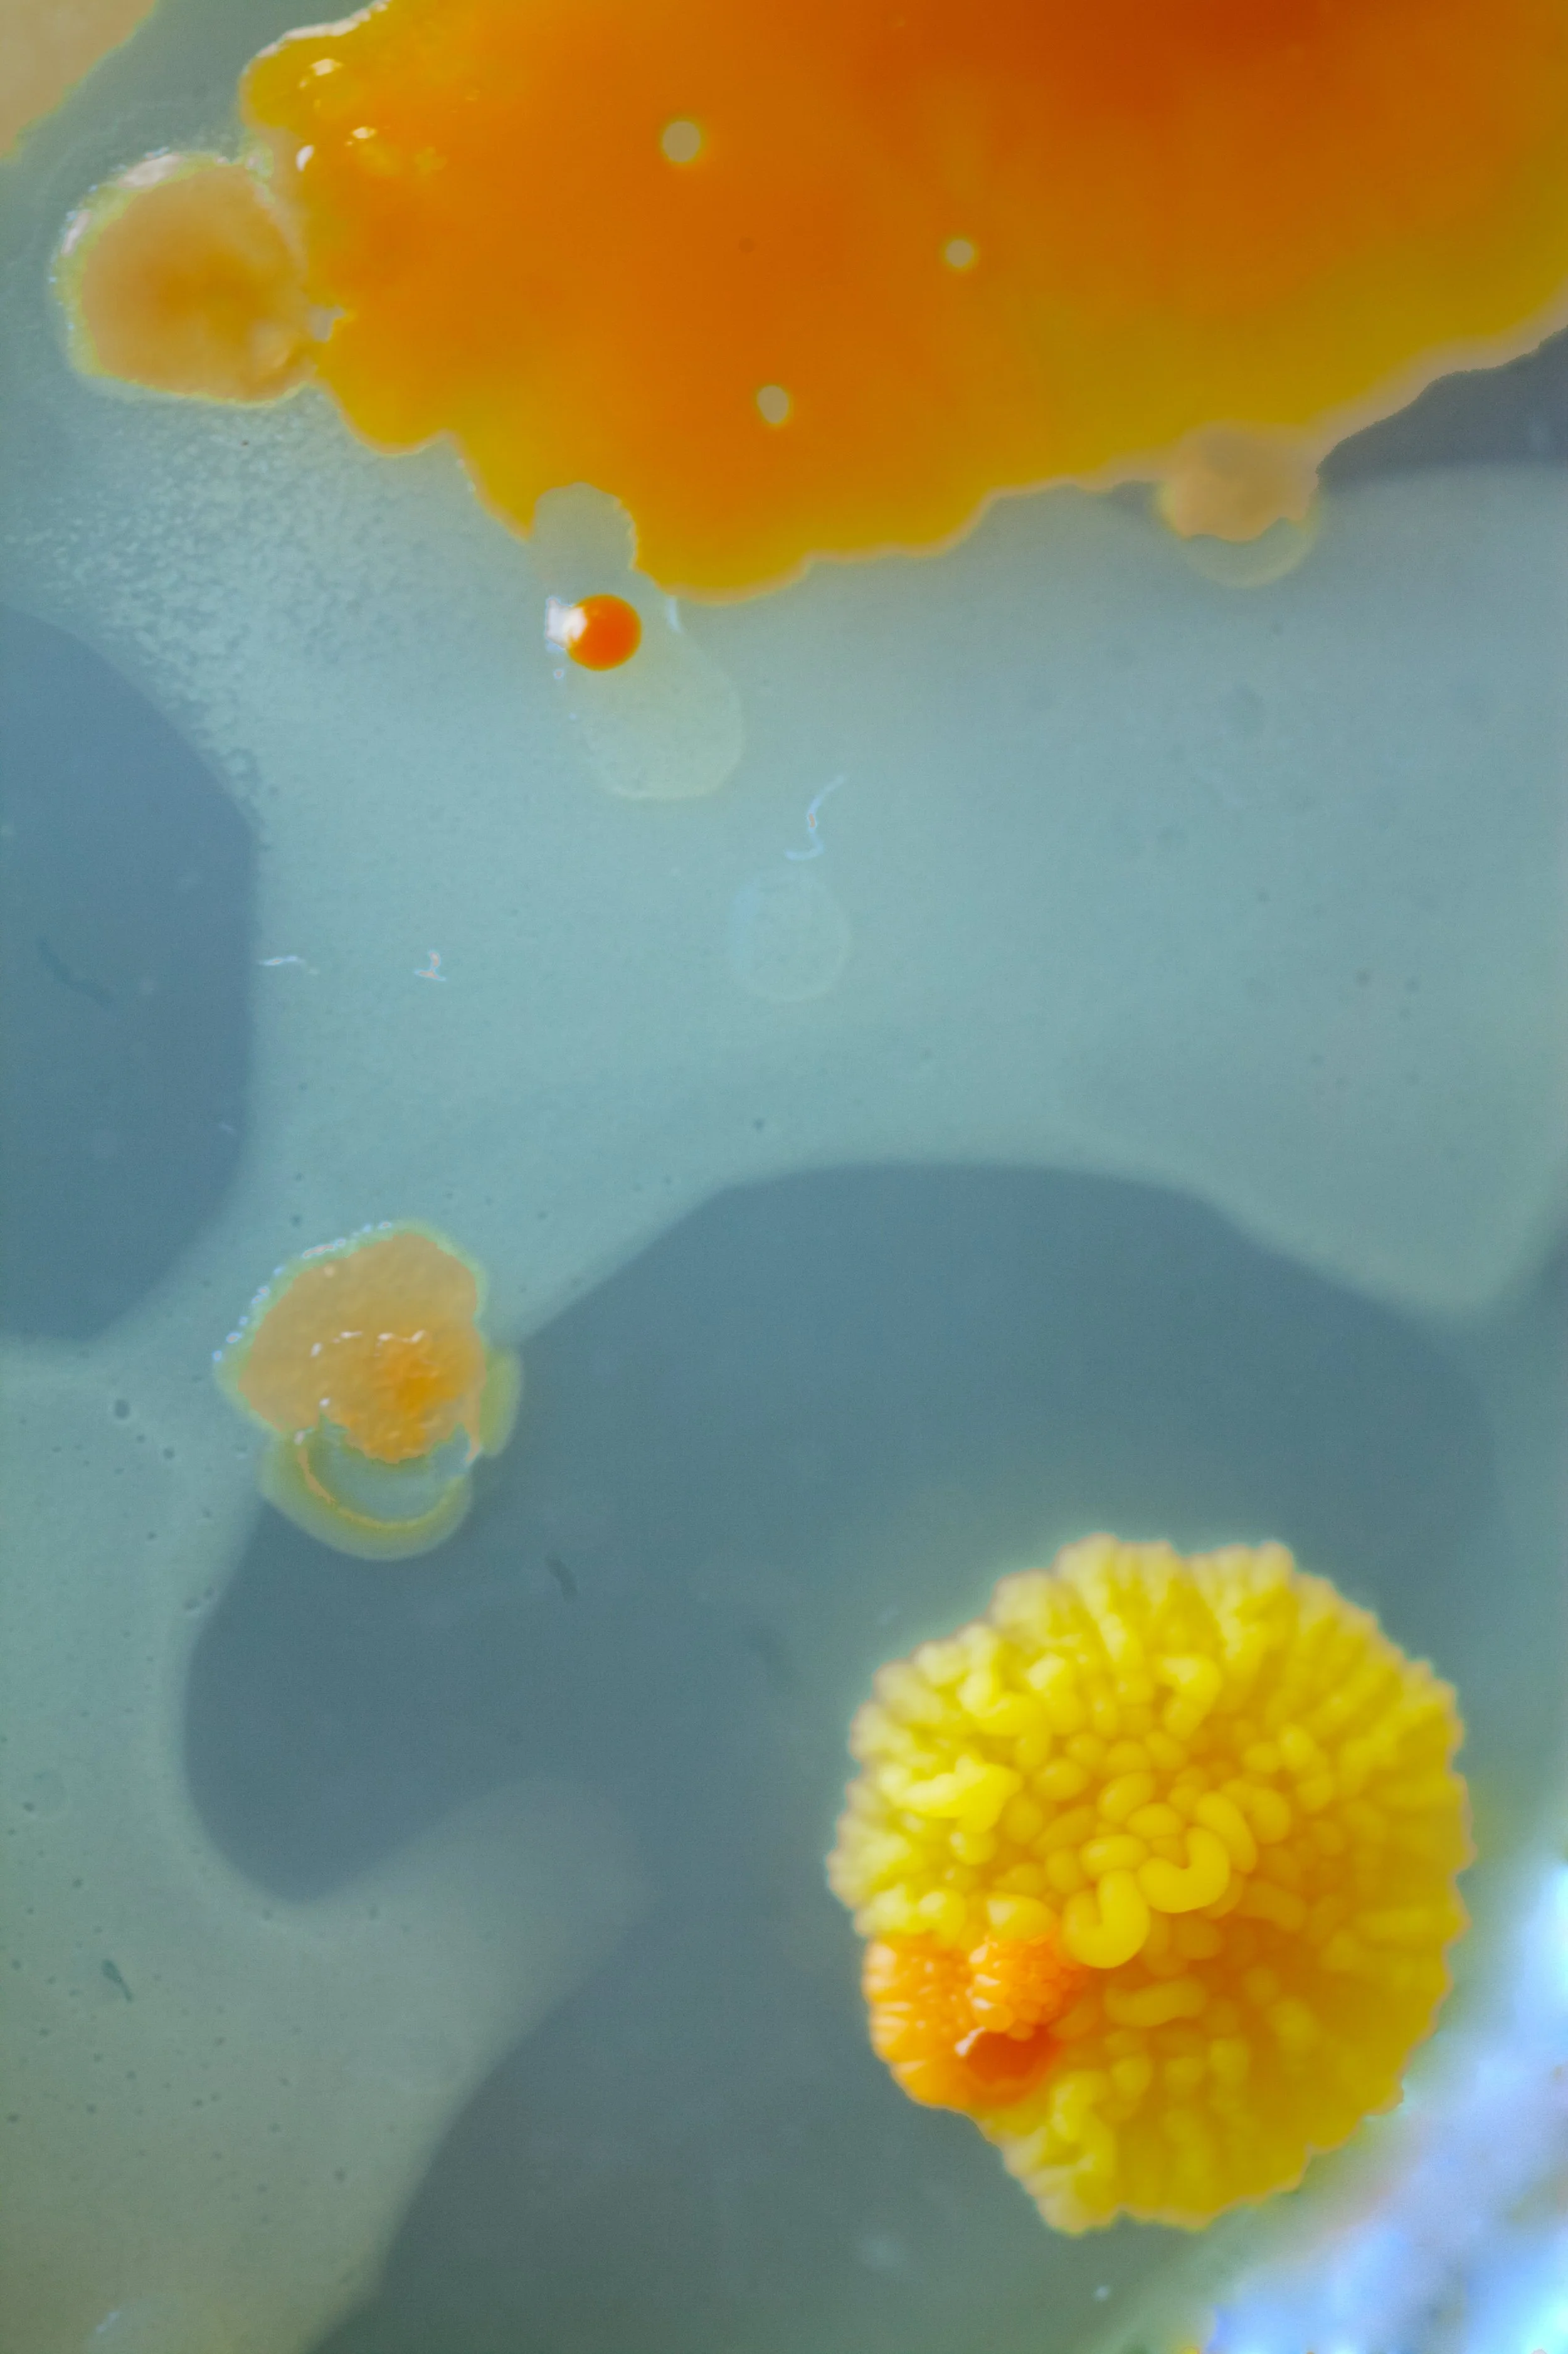
26IMG_0034 01.jpg

Ordinary
Milk
Cultivated human breastmilk microbial cultures, Archival inkjet print on fine art paper.
Ordinary Milk visualises breastmilk as both biological and political labour. Cultivating and photographing microbial cultures from her own milk, the artist reveals its rich, unseen ecosystems, challenging taboos that render human milk invisible while other milks are normalised and commodified. The work exposes how capitalism devalues maternal care, treating breastfeeding as private duty rather than essential, skilled labour that sustains life and community.
A still growing body of work.